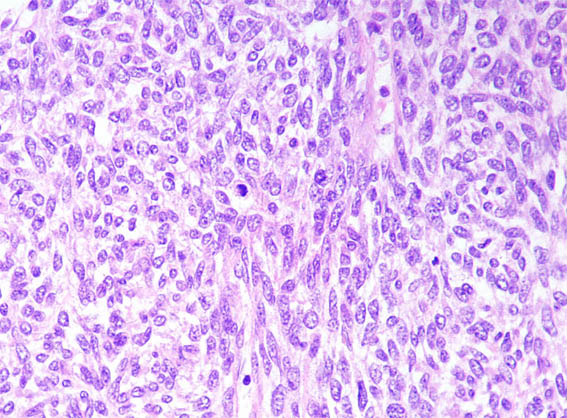
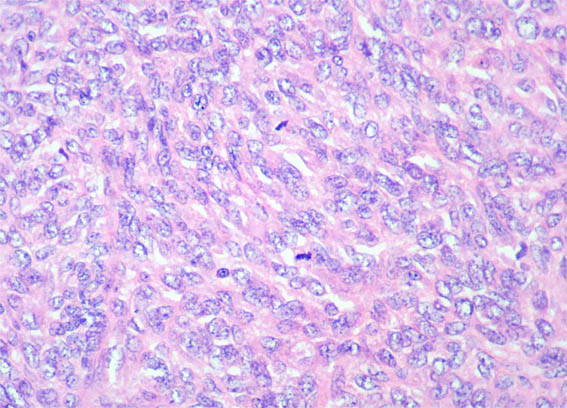
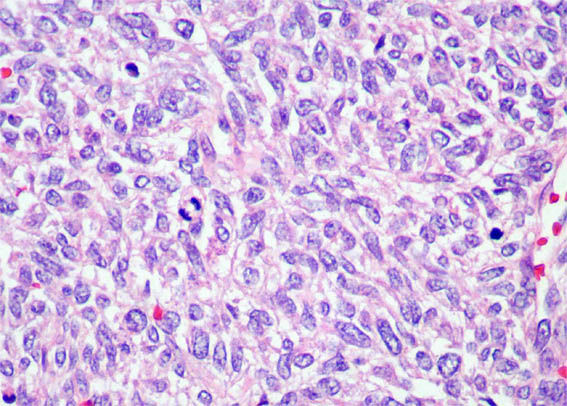

|
|
CASE
138 (August 2017)
Clinical information
The patient is a 2-month-old boy in whom his mother palpates abdominal mass. Image studies demonstrate mass that compromises more than 50% of the left kidney.
Nephrectomy is done. Look at the pictures.

Figure 1. Fragments of nephrectomy specimen after selection of sections for histology.

Figure 2. H&E, X100.

Figure 3. H&E, X100.

Figure 4. H&E, X100.

Figure 5. H&E, X200.

Figure 6. H&E, X200.
Figure 7. H&E, X400.
Figure 8. H&E, X400.
Figure 9. H&E, X400.
What is your diagnosis?
See
diagnosis and discussion
[Top]
|
|